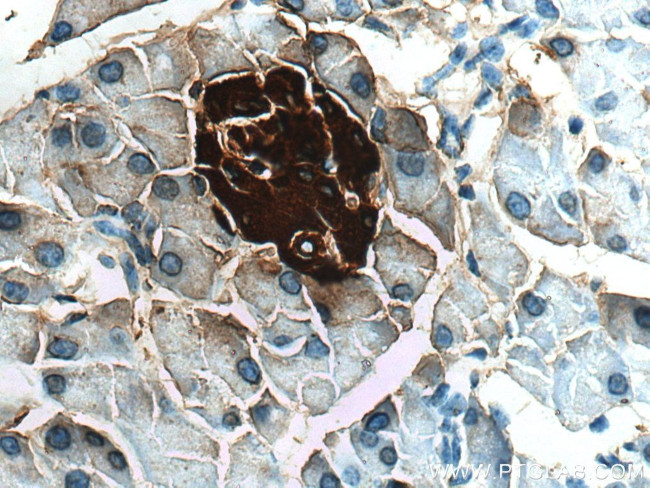
Ins1 Antibody in Immunohistochemistry (Paraffin) (IHC (P))

Search
Proteintech
Ins1 Polyclonal Antibody
{{$productOrderCtrl.translations['antibody.pdp.commerceCard.promotion.promotions']}}
{{$productOrderCtrl.translations['antibody.pdp.commerceCard.promotion.viewpromo']}}
{{$productOrderCtrl.translations['antibody.pdp.commerceCard.promotion.promocode']}}: {{promo.promoCode}} {{promo.promoTitle}} {{promo.promoDescription}}. {{$productOrderCtrl.translations['antibody.pdp.commerceCard.promotion.learnmore']}}
产品信息
28609-1-AP150UL
种属反应
宿主/亚型
分类
类型
偶联物
形式
浓度
规格
纯化类型
保存液
内含物
保存条件
运输条件
靶标信息
Insulin is a peptide hormone secreted by beta cells of the pancreatic islets. It regulates carbohydrate, protein and lipid metabolism by enhancing membrane transport of glucose, amino acids, and certain ions. It also promotes glycogen storage, formation of triglycerides and synthesis of proteins and nucleic acids. Insulin is 51-amino acid polypeptide product produced from a precursor peptide, proinsulin. Proinsulin is post-translationally cleaved into two chains (peptide A and peptide B) that are covalently linked via two disulfide bonds and one molecule of C-peptide. Insulin deficiency results in diabetes mellitus, one of the leading causes of morbidity and mortality in the general population. Insulin is also present in tumors of b-cell origin such as insulinoma.
仅用于科研。不用于诊断过程。未经明确授权不得转售。
篇参考文献 (0)
生物信息学
蛋白别名: Ins; Insulin-1; Insulin-2
基因别名: AA986540; Ins-1; Ins-2; Ins1; Ins2; Ins2-rs1; InsII; Mody; Mody4; proinsulin
UniProt ID: (Rat) P01322, (Mouse) P01325, (Rat) P01323, (Mouse) P01326
Entrez Gene ID: (Rat) 24505, (Mouse) 16333, (Rat) 24506, (Mouse) 16334